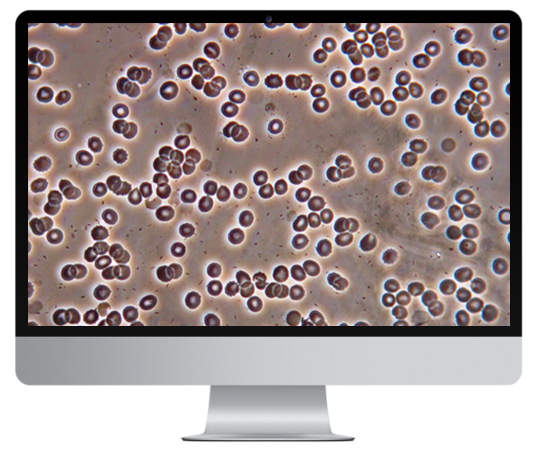

八十年代末,美國學者,R.M.bradford率先推出布氏顯微鏡,其應用先進的氧自由基理論,全息胚學說,細胞形態(tài)學,只需采取人體指尖的一滴血,將其細胞放大20000倍,通地顯示器顯示活體圖像,直觀地看到各種細胞形態(tài)及活動情況,(包括紅細胞,白細胞,膽固醇,乳糜微粒,血小板等變異情況)將可能發(fā)生的隱患消來在萌芽狀態(tài),在西方及其歐美國家被予為健康的“保護神”和“預警器”顯微領域里的“CT”,該檢測法也稱為“一滴血檢測”。
一滴血檢測將人體末稍血液放大一萬多倍的情況下,血細胞的形態(tài)活力變異,代謝產(chǎn)物、血管壁的脫落物以及細菌等各種有形成份,都會逼真地展現(xiàn)在我們面前,為人類捕捉各種早期病變成為可能。也是亞健康狀態(tài)群體及無臨床癥狀的疾病早期最可靠的檢測方法。一滴血檢測儀現(xiàn)在廣泛應用于保健品、藥品療效研究、公安刑偵、科研等,是機構作為教學研討、商業(yè)演示的有效手段。
特點:
多——信息量多。
快——快速檢測。
好—--無痛、無副作用,不會感染,也絕對沒有環(huán)境污染。
省——省時、省錢;活血、干血檢查一氣呵成,5分鐘就可以了解全身健康狀況。
準——結果準確;準確率95%左右。
項目 |
參數(shù) |
目鏡 |
大視野WF10X(Φ18mm) |
物鏡 |
消色差 4X/0.10 |
消色差 10X/0.25 |
|
相襯消色差 40X/0.65 PHP(彈簧) |
|
目鏡筒 |
三目鏡(傾斜30°) |
調(diào)焦機構 |
粗微動同軸調(diào)焦,微動格值:2μm. |
轉(zhuǎn)換器 |
四孔(外向式滾珠內(nèi)定位) |
載物臺 |
雙層機械移動式(尺寸:135mm*125mm,移動范圍:75mm*35mm) |
聚光鏡 |
拉板式相襯聚光鏡 |
濾色片 |
藍濾色片 綠濾色片 |
光源 |
6V20W鹵素燈,亮度可調(diào) |
接口 |
C型接口 |
攝像頭 |
480線彩色攝像頭,含線 |